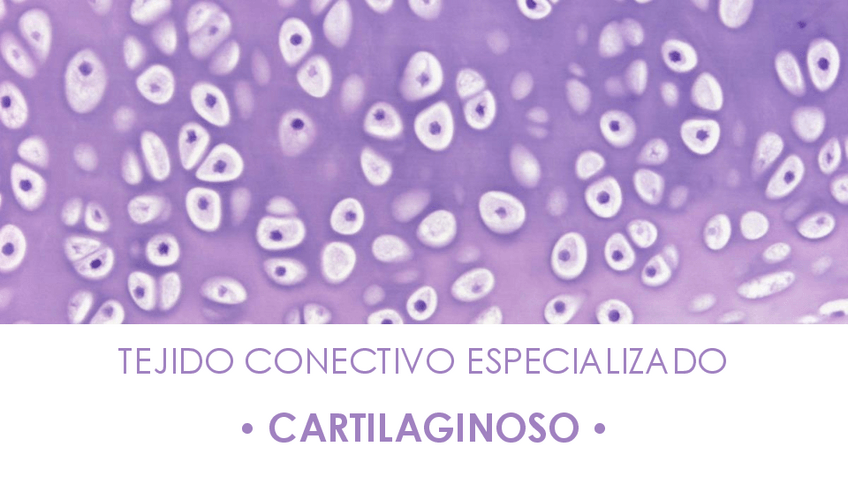

Licenciatura en Kinesiología y Fisiatría (UBA)
Buenos Aires
Sube tus apuntes
arrow_forwardAsignaturas de Licenciatura en Kinesiología y Fisiatría (UBA)
Asignatura
arrow_downward1º
•
9 posts
1º
•
8 posts
1º
•
5 posts
2º
•
17 posts
4º
•
0 posts
5º
•
0 posts
2º
•
0 posts
3º
•
0 posts
1º
•
8 posts
2º
•
1 posts
3º
•
0 posts
3º
•
5 posts
5º
•
0 posts
5º
•
0 posts
4º
•
0 posts
5º
•
0 posts
3º
•
0 posts
4º
•
0 posts
1º
•
27 posts
4º
•
0 posts
2º
•
0 posts
2º
•
0 posts
3º
•
1 posts
2º
•
0 posts
3º
•
0 posts
4º
•
0 posts
Últimas publicaciones de Licenciatura en Kinesiología y Fisiatría (UBA)
Resumen módulo de introducción a la kinesiología y fisiatría 2025 Bloque kinesiología
Resumen de modulo de introducción a la kinesiología y fisiatría, Bloque discapacidad 1er cuatrimestre 2025
He publicado nuevos apuntes de 1º Biología Celular: Biologia-Celular-Final-de-Julio-2011-Tema-4-Con-grilla.pdf
He publicado nuevos apuntes de 1º Biología Celular: Primer-parcial-kinesio-16-7-22.pdf
He publicado nuevos apuntes de 1º Anatomía: RESUMEN-1ER-PARCIAL-ANATO.pdf
He publicado nuevos apuntes de 1º Anatomía: Rouviere-Anatomia-9ed-T3.pdf
He publicado nuevos apuntes de 1º Anatomía: ANATOMIA-MODULO-1-PDF.pdf
He publicado nuevos apuntes de 1º Biofísica: BIOFISICA-primer-parcial.pdf
He publicado nuevos apuntes de 1º Biofísica: primer-parcial-resumen.pdf
He publicado nuevos apuntes de 1º Psicología Médica: Guia-de-preguntas-de-unidades.pdf
He publicado nuevos apuntes de 1º Psicología Médica: psicologia-medica-resumen.pdf
He publicado nuevos apuntes de 1º Psicología Médica: Psicologia-Medica-1P.pdf
He publicado nuevos apuntes de 1º Psicología Médica: La-Psicologia-Medica-como-ciencia-Objeto-y-Metodo.pdf
He publicado nuevos apuntes de 1º Psicología Médica: DOC-20230705-WA0003..pdf
He publicado nuevos apuntes de 1º Módulo de Introducción a la Kinesiología y Fisiatría: TODOS-LOS-THI.pdf
He publicado nuevos apuntes de 1º Psicología Médica: psicologia-medica-resumen-1er-parcial.pdf
He publicado nuevos apuntes de 1º Psicología Médica: RESUMEN-2DO-PARCIAL-PSICOLOGIA-MEDICA.pdf
He publicado nuevos apuntes de 1º Fisiología: RESUMEN3ERPARCIALFISIO.pdf
He publicado nuevos apuntes de 1º Fisiología: 3er-Modulo-de-FISIOLOGIA-Apunte.pdf
He publicado nuevos apuntes de 1º Psicología Médica: 7_ Esquema-e-imagen-corporal.pdf
He publicado nuevos apuntes de 1º Psicología Médica: 7_ Esquema-Corporal-e-Imagen-del-Cuerpo.pdf
He publicado nuevos apuntes de 1º Psicología Médica: 7_ El-Cuerpo-para-el-Psicoanalisis.pdf
He publicado nuevos apuntes de 1º Biología Celular: TP-3-Tejido-Cartilago-Oseo-Kinesio-2022.pdf
He publicado nuevos apuntes de 1º Biología Celular: TP4-y-TP5-MUSCULAR-Y-CARDIO-KINESIO.pdf
He publicado nuevos apuntes de 1º Biología Celular: TP-7-sangre-y-med-osea-kinesio.pdf
He publicado nuevos apuntes de 1º Fisiología: Lopez-Magdalena-Cap-1.pdf
He publicado nuevos apuntes de 1º Fisiología: Lopez-Magdalena-Cap-2.pdf
He publicado nuevos apuntes de 1º Fisiología: Lopez-Magdalena-Cap-3.pdf
He publicado nuevos apuntes de 1º Fisiología: Lopez-Magdalena-Cap-4.pdf
He publicado nuevos apuntes de 1º Psicología Médica: 1-Teoria-de-la-comunicacion.pdf
He publicado nuevos apuntes de 1º Psicología Médica: 2-EL-PACIENTE-CON-DOLOR.pdf
He publicado nuevos apuntes de 1º Psicología Médica: 3-EL-KINESIOLOGO-Y-LA-PSICOTERAPIA.pdf
He publicado nuevos apuntes de 1º Psicología Médica: 4-REHABILITACION-ORTOPEDIA-Y-PSIQUIATRIA.pdf
He publicado nuevos apuntes de 1º Psicología Médica: 5-LA-RELACION-MEDICO-PACIENTES-EN-UCI.pdf
He publicado nuevos apuntes de 1º Psicología Médica: 6-ENFERMEDADES-CRONICAS.pdf
He publicado nuevos apuntes de 1º Psicología Médica: 7-ASPECTOS-PSIQUIATRICOS-Y-PSICOANALITICOS-EN-LAS-ENFERMEDADES-NEUROLOGICAS.pdf
He publicado nuevos apuntes de 1º Psicología Médica: La-relacion-Asistente-Asistido-como-Institucion.pdf
apuntes
-
Unidad 4
He publicado nuevos apuntes de 1º Psicología Médica: Unidad 4
apuntes
-
Unidad 3
He publicado nuevos apuntes de 1º Psicología Médica: Unidad 3
apuntes
-
Rouviere - Tomo 1
He publicado nuevos apuntes de 1º Anatomía: Rouviere - Tomo 1